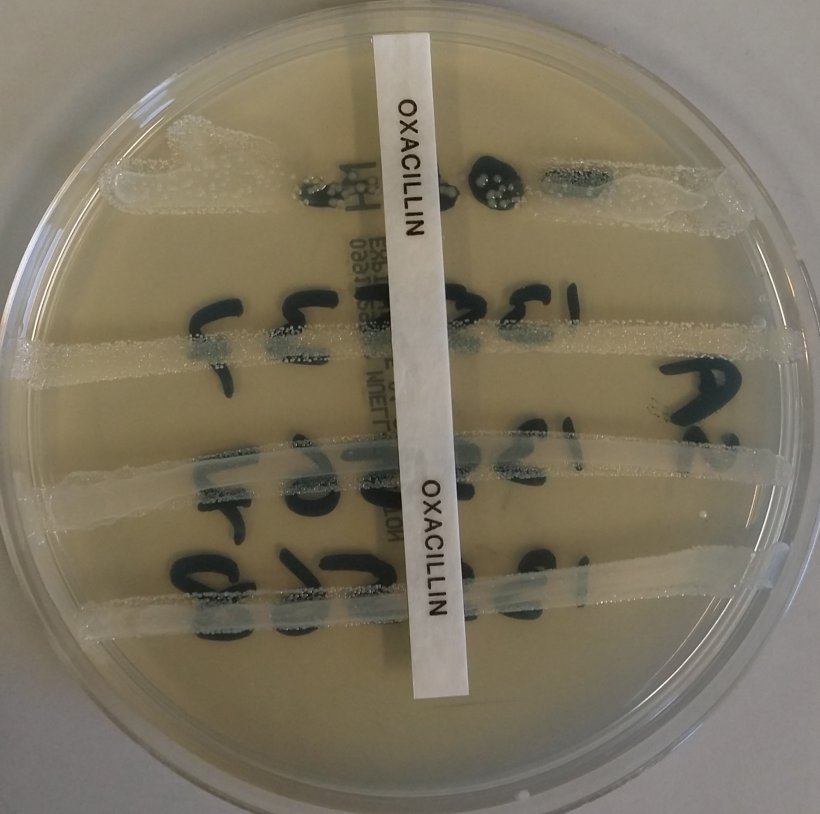
resistência antimicrobiana

A Comissão, dentro do «Plano de Acção Europeu “Uma só saúde” para lutar contra a resistência aos antimicrobianos», comprometeu-se a rever a legislação relativa à vigilância da resistência aos antimicrobianos (RAM) em bactérias zoonóticas e comensais em animais de produção e nos alimentos.
- Entre 2015 e 2018, a Comissão levou a cabo uma série de auditorias nos Estados Membros com a finalidade de avaliar a aplicação da Decisão de Execução 2013/652/UE por parte das autoridades competentes que evidenciou que os Estados Membros apresentam dificuldades na sua aplicação.
- Em 2019, a Autoridade Europeia de Segurança Alimentar (EFSA) publicou um relatório científico intitulado Technical specifications on harmonised monitoring of antimicrobial resistance in zoonotic and indicator bacteria from food‐producing animals and food [«Especificações técnicas sobre a vigilância harmonizada da resistência aos antimicrobianos nas bactérias zoonóticas e indicadoras provenientes de alimentos e de animais produtores de alimentos»]. Este relatório recomenda adaptações específicas ao actual sistema de vigilância e notificação da RAM com a finalidade de responder eficazmente à ameaça da RAM, em constante evolução e garantir a continuidade na avaliação das futuras tendências da RAM a partir de 2021. Estas adaptações recomendadas referem-se, principalmente, às populações de animais produtores de alimentos ou às categorias de alimentos que devem ser alvo de amostragem, à definição da amostragem que se deve seguir, às espécies bacterianas que se devem submeter a ensaio para detectar a RAM e aos métodos analíticos que devem utilizar os laboratórios encarregados dos ensaios de RAM.
- Por outro lado, para continuar a obter dados comparáveis e fiáveis sobre a RAM, é importante ter em conta as recomendações do relatório científico da EFSA no momento de definir as combinações mais pertinentes de espécies bacterianas, espécies de animais produtores de alimentos e de produtos alimentares que se devem incluir no sistema harmonizado de vigilância e notificação da RAM a partir de 2021. Também é conveniente reduzir, na medida do possível, a carga que pesa sobre as autoridades competentes dos Estados Membros, em particular abordando as dificuldades de aplicação conhecidas e centrando a vigilância da RAM em amostras biológicas ou estirpes bacterianas que já se tenham recolhido no âmbito dos programas nacionais de controlo existentes.
- Além disso, a sequenciação do genoma completo (WGS) é uma técnica prometedora para substituir os ensaios fenotipicos convencionais em microbiologia e utiliza-se cada vez mais em todo o mundo. Contudo, só um número limitado de Estados Membros têm, actualmente, capacidade de utilizar a WGS de forma rotineira para vigilância da RAM. É por isso que a nova legislação autoriza o uso da WGS unicamente como alternativa com carácter voluntário, mas impondo condições técnica à WGS para garantir a comparabilidade dos dados.
- Tendo em conta que a RAM é uma ameaça mundial que se pode propagar facilmente através das fronteiras, é esesncial que os produtos alimentares importados pela UE também estejam sujeitos a requisitos de vigilância da RAM.
DECISÃO DE EXECUÇÃO (UE) 2020/1729 DA COMISSÃO

19 de Novembro de 2020/ EURLEX/ União Europeia.
https://eur-lex.europa.eu